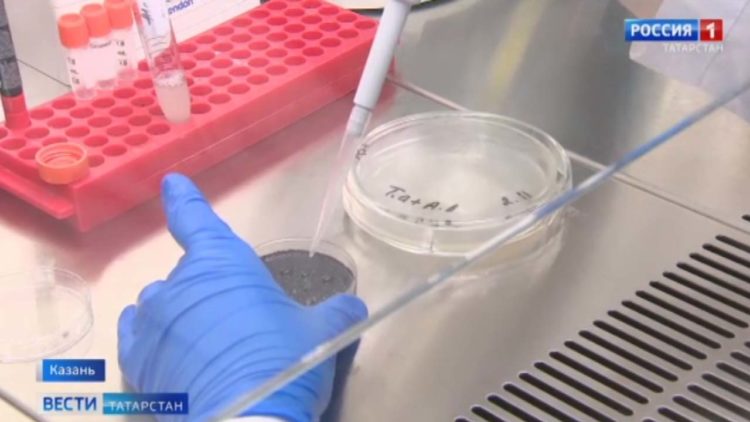
Владимир Путин назначил Ирека Файзуллина главой Минстроя РФ

Яңалыклар (11.11.20)
Иртәнге чыгарылыш.
Татарстан Хөкүмәте һәм Перспективалы тикшеренүләр фонды арасында хезмәттәшлек турында килешү имзаланды.
2021 елның гыйнварыннан Пенсия фонды бүлекчәләре хезмәт күрсәтүне «Минем документлар» офисына күчерәчәк.
Татарстанда 14 ноябрьгә кадәр «Абилимпикс» республика чемпионаты уза.
Көндезге чыгарылыш.
Татарстан предприятиеләре ташламалы кредитлау программасы буенча 6 мең 500гә якын кредит алды.
Республика клиник хастаханәсенә кан плазмасы донорларын чакыралар.
Казанның Мәскәү районында «Табибларга рәхмәт» дигән граффити барлыкка килде.
Кичке чыгарылышлар.
«Алабуга» махсус икътисадый зонасы илнең махсус икътисадый зоналары арасында үзенең лидерлыгын чираттагы тапкыр раслады.
Татарстан Авыл хуҗалыгы һәм азык-төлек министрлыгында «Контроль сәгате» форматында киңәшмә узды.
Узган тәүлектә Татарстанда Covid -19 инфекциясе белән зарарлануның 55 яңа очрагы теркәлгән.
«Алабуга» махсус икътисадый зонасы илнең махсус икътисадый зоналары арасында үзенең лидерлыгын чираттагы тапкыр раслады.
Бүген Татарстан Президенты Рөстәм Миңнеханов Тунис Республикасының Россия Федерациясендәге Гадәттән тыш һәм Тулы вәкаләтле Илчесе Тарак бен Салем белән очрашты.
Узган тәүлектә Татарстанда Covid -19 инфекциясе белән зарарлануның 55 яңа очрагы теркәлгән.
Нашли опечатку? Выделите фрагмент и отправьте нажатием Ctrl+Enter
Поделиться новостью:
Лента новостей
Блог

ГТРК "Татарстан", 420095, г.Казань, ул.Шамиля Усманова, 9
Телефон редакции:
8 (843) 528-25-59
Электронная почта редакции ГТРК:
vesti@trttv.ru16+
«Государственный Интернет-Канал «Россия» (свидетельство о регистрации Эл № ФС 77-59166 от 22.08.2014, выдано Федеральной службой по надзору в сфере связи, информационных технологий и массовых коммуникаций)
Учредитель – федеральное государственное унитарное предприятие «Всероссийская государственная телевизионная и радиовещательная компания»
Главный редактор - Панина Елена Валерьевна, редактор ГТРК - Гималтдинов Фирдус Салихович
При любом использовании текстовых, аудио-, фото- и видеоматериалов ссылка на trt-tv.ru обязательна. При полной или частичной перепечатке текстовых материалов в интернете гиперссылка на trt-tv.ru обязательна. Для детей старше 16 лет.
На информационном ресурсе применяются рекомендательные технологии (информационные технологии предоставления информации на основе сбора, систематизации и анализа сведений, относящихся к предпочтениям пользователей сети "Интернет", находящихся на территории Российской Федерации)
© 2025 Государственная телерадиокомпания «Татарстан»